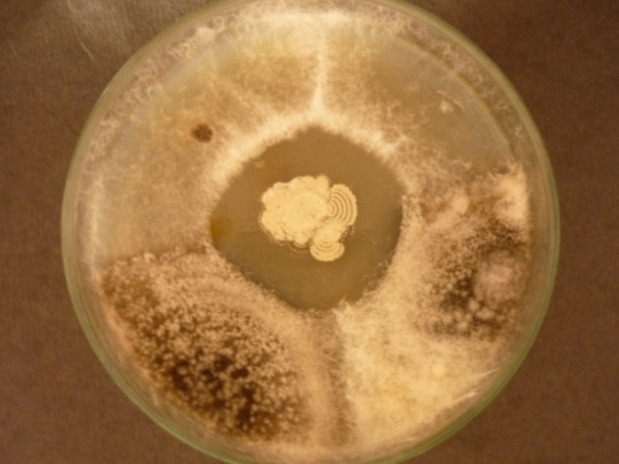

1, 2Department of Biotechnology, Faculty of Science and Humanities, SRM University, Kattankulathur, Tamilnadu, India, 3Department of Microbiology, Bharathidasan University Constituent College, Kurumbalur 621107, Perambalur district, Tamilnadu, India.
Email: microthiru08@yahoo.com
Received: 13 Jan 2015 Revised and Accepted: 10 Feb 2015
ABSTRACT
Objective: The objective of the present study was aimed to isolate actinobacteria from the marine environment and to screen the production and antifungal activity of chitinase enzyme against phytopathogenic fungi.
Methods: The actinobacteria were isolated from twelve sediment samples of East Coast Regions (ECR) by spread plate technique on starch casein agar, and the actinobacteria isolates were identified by the methods of International Streptomyces Project (ISP). All the actinobacteria were tested for chitinase activities using enrichment chitin agar media (EMCA) by spot inoculation method, and the potential isolate was used for chitinase production by submerged fermentation technique using 1% colloidal chitin in liquid medium. The efficacy of chitinase activity was assessed by spectrophotometric method along with growth monitoring. The most potential isolate Streptomyces sp. ACT7 was evaluated for its antagonistic activity against phytopathogens namely F. oxysporum and Alternaria sp. by dual culture method.
Results: Totally, 27 isolates of actinobacteria were isolated from marine sediments of ECR. Of them, 9 isolates had chitinase activity. Among the chitinase producers, the isolate ACT7 had prominent chitinase production after 7 days of incubation. The antagonistic activity of the isolate ACT7 was effective in restricting the radial growth of phytopathogens such as F. oxysporum and Alternaria sp.
Conclusion: The actinobacteria has found to possess potent antifungal activity and it can be used as a promising biocontrol agent, thereby reducing the use of chemical fungicides.
Keywords: East coast region, Sediments, Streptomyces, Chitinase, Biocontrol, Phytopathogens.
INTRODUCTION
The Ocean covers over 70% of the earth's surface and provides the largest inhabitable space for microbial community [1]. The marine environment represents a rich and untapped reservoir for isolation of new microorganisms with novel natural products [2]. There are numerous biologically active secondary metabolites derived from various microbial sources possessing anti-microbial and anti-cancer effects and are commercially available in the market. Since last two decades, the discoveries of novel compounds from actinobacteria have yielded high numbers of pharmaceutically valuable secondary metabolites [3]. Currently, majorities of natural products are of marine bacterial origin and have arisen from a small number of taxonomic groups that include Streptomyces, Alteromonas, Pseudomonas, Vibrio, Agrobacterium and cyanobacteria [4, 5]. Among these, Streptomyces is commonly used in pharmaceuticals, agrochemicals industries and mainly has a great commercial value in the food industry.
Chitin is the second most abundant linear polymer composed of β-1, 4-linked N-acetylglucosamine (GlcNAc), and it is present in all major groups of microorganisms viz., bacteria, fungi, plants and animals [6]. Chitinase contains glycosyl hydrolases enzyme which catalyses the degradation of chitin to its oligomers (chitooligosaccharides) and monomers (N-acetylglucosamine). Chitooligosaccharides and their N-acetylated analogues are proven to possess specific biological activities such as antimicrobial activity, antitumor activity, immuno-enhancing effects [7]. Several chitinolytic enzymes have been identified from various Streptomyces sp., including, S. lividans [8], S. virdificans [9] and S. halstedii [10]. They are used widely in agricultural, biological and environmental sectors [11]. In recent years, natural microbial metabolites have become the viable biocontrol source to treat fungal disease in plants and are proven to be a more efficient source than synthetic fungicides. Thus, the present study dealt with the isolation, identification and characterizations of marine actino bacteria from the east coast region (ECR) for enzyme production and screening of their antifungal activity.
MATERIALS AND METHODS
Collection of soil samples
Marine sediment samples were collected from an estuary of East Coast Regions (ECR) of Tamilnadu, South India. These samples were transferred into sterile polyethylene bags immediately after collection, sealed, labeled and stored in refrigerator. Then the samples were air dried and heat treated in an oven at 40°C to reduce the numbers of vegetative bacterial cells [12] and stored at 4°C for further use. Then the sample was serially diluted and spread plate technique was employed for the isolation of actinobacteria on 50% aged sea water in starch casein agar (SCA). The medium was added with cyclohexamide 25µg/ml and nalidixic acid 20µg/ml for the prevention of bacterial and fungal contaminations [13]. After incubation at 28ºC for 7 to 15 days, the actinobacterial colonies were purified and sub-cultured in SCA medium.
Primary screening for enzyme production
Spot inoculation method was used for screening of actinobacteria for its ability to produce chitinase on enrichment agar media [17] and the same were incubated at 30°C for 7-10 days. Colonies with zones of clearance against the creamy background were regarded as chitinase-producing actinobacteria and the colony diameter was recorded. The most efficient isolate (ACT7) was selected for further studies on the basis of the zone of hydrolysis.
Extracellular chitinase activity
The potential actinobacteria was inoculated in liquid chitin medium [18] and incubated at 30 °C with shaking at 160 rpm for 7-10 days. The supernatant was collected every two days in the subsequent 10 days and filtered using Whatman No.1 filter paper. Chitinase activity in the supernatant was assayed using 0.6% colloidal chitin as substrate [19]. Then 700 μl of supernatant was added to 300 μl of 2% colloidal chitin in 0.1 M potassium phosphate buffer at pH 7.0. Then the mixture was incubated at 40 °C for 3 h. One ml of Somogyi’s reagent was added and the reaction mixture was boiled at 100ºC for 10 min and then cooled to room temperature [20]. To the mixture 1 ml of Nelson’s reagent was added and the mixture was cooled to room temperature for 20 min. After centrifugation of the reaction mixture, the amount of N-acetyl glucosamine (GlcNAc) released into the supernatant was measured using spectrophotometer at 520 nm. The principle used was the formation of a colored complex due to the reaction between copper-oxidized sugar and arsenomolybdate [20]. One unit (U) of chitinase activity was defined as the amount of enzyme required to produce 1 µmol. of reducing sugar per minute under the conditions of the experiment. The cell growth was followed by measurement of the cells dry weight. After removing the supernatant for chitinase assay, the cell pellet was dried in an oven at 80 °C until a constant weight was obtained. All the measurements were performed in triplicate.
Screening of actinobacteria for antifungal activity
The isolate ACT7 was evaluated for its antagonistic activity against two fungal phytopathogens such as F. oxysporum and Alternaria sp. by dual culture method. An agar plug of 6 mm in diameter was taken from a 5 days old colony of both the test fungus and was inoculated from 20 mm away from both sides to the original plug of 7 days old actinobacterial culture. The control plates were also maintained with test fungi alone without actinobacterial isolate. The plates were then incubated at 30 °C for 2-3 days, and the inhibition zone of fungal growth was measured. The results were noted with triplicative method.
Characterization of actinobacteria
Actinobacteria with superior chitinase activity was identified on the basis of their morphological (aerial spore mass color, reverse side and melanoid pigments and spore chain morphology), physiological and biochemical characteristics by standard methods of Jensen et al. [14] and ISP [15]. The purified colonies were streaked in SCA and incubated. Matured sporulating aerial mycelial color and reverse side pigment of the colonies, like distinctive (+) and not distinctive (-) were recorded. The spore bearing hyphae and spore chain morphology of the actinobacteria were determined by direct microscopic examination under 1000X magnification by cover slip method. The spore surface morphology of mycelium was observed using 7-10 days old culture under Scanning Electron Microscope (SEM) [16].
RESULTS AND DISCUSSION
In the present study, a total of 101 actinobacterial colonies was isolated from marine sediments of ECR, Tamilnadu, India. From these 101 colonies, 27 were morphologically distinguished isolates. The actinobacterial isolates were produced powdery colonies with different aerial mass color and reverse side pigments (red, black, white, ash, brown and yellow/orange) (table 1).
All the morphologically different isolates were primarily screened for the production of chitinase enzyme. Out of 27 morphologically different isolates, 9 (33.3%) isolates produced chitinase enzyme against the EMCA agar. Among these chitinase producing isolates, the isolate ACT7 produced remarkable largest clear zone on EMCA agar plate and it was identified as the most potent producer of chitinase enzyme. The potential isolate were produced in small to medium size, white, ash, green and brown colored, circle shaped, powdery with regular marginal colonies with gray, black, red and golden yellow colored reverse sides. Similarly, it was previously reported that different colored and sized actinobacteria colonies were isolated and reported [5]. The most potential isolate ACT7 showed powdery yellowish white colored colonies and did not produce any reverse side pigments. The electron microscopic study revealed 21-50 numbers of smooth surfaced aerial spores and globose shaped rectiflexibles spore chain were observed. The isolate was positive for the biochemical characteristics such as production of citrase, amylase, cellulase, catalase and oxidase and negative for H2S production, haemolysis and urease (table 2). Based on the above characterization, the isolate ACT7 was identified as Streptomyces sp. and the zone of clearance in enrichment agar media indicated that Streptomyces sp. ACT7 was the most potent strain chitinase producer than other isolates.
Table 1: cultural characteristics of antifungal actinobacteria
| S. No. | Isolate code | Aerial mass color | Reverse side pigment |
| 1 | ACT1 | White | - |
| 2 | ACT3 | Light ash yellow | - |
| 3 | ACT4 | Ash | Black |
| 4 | ACT7 | Yellowish white | - |
| 5 | ACT16 | Ash | Yellow |
| 6 | ACT21 | White | Red |
| 7 | ACT25 | White | Yellow |
| 8 | ACT27 | Greenish ash | Brownish black |
Table 2: Morphological characterization of potential actinobacterial isolate ACT7
S. No. |
Characterization |
|||
Morphological |
Result |
Biochemical |
Result |
|
1 |
Presence of aerial and substrate mycelia |
+ |
Citrase |
+ |
2 |
Spores in aerial mycelium |
+ |
Amylase |
+ |
3 |
No. of spores |
21-50 |
Catalase |
+ |
4 |
Shape of spores |
Globose |
oxidase |
- |
5 |
Spore chain morphology |
Rectiflexibles |
Cellulase |
+ |
6 |
Spore surface |
Smooth |
H2S |
- |
7 |
Aerial mycelium colour |
White |
Haemolysis |
- |
8 |
Reverse side colour |
- |
Urease |
- |
+Positive,-Negative
The efficacy of the chitinase production by the isolate ACT7 was studied by submerged fermentation method using 1 % colloidal chitin. When chitinase activity of ACT7 was assessed, there was a gradual increase in chitinase production up to 168 h. (0.54±0.57-1.10±0.14 U/ml) after which chitinase activity was decreased (table 3). The initial pH of production medium was 8.0; it was declined to 6.5 within the first 60 h. after which it was increased up to 8.5 during 144 h. after the chitinase produciton. In nature chitinase is produced by actinobacteria in order to degrade complex nutrients present in the soil. As fungal cell wall structures largely contain chitin, chitinase produced by actinobacteria can be deleterious to both pathogens and pests [21].
Table 3: chitinase production and cell dry weight of Streptomyces sp. ACT7
| S. No. | Days | Chitinase (U/ml) | Cell dry weight (g/100 ml) |
| 1 | 0 | 0.00±0.00 | 0.04±0.05 |
| 2 | 2 | 0.54±0.57 | 0.07±0.07 |
| 3 | 4 | 0.80±0.83 | 0.09±0.10 |
| 4 | 6 | 1.10±0.14 | 0.18±0.18 |
| 5 | 8 | 1.05±0.18 | 0.15±0.15 |
| 6 | 10 | 0.90±0.93 | 0.15±0.16 |
Values in each column are the mean of three replicates±SD
Antifungal activity
The enzymatic activity of Streptomyces sp. ACT7 revealed that this isolate could effectively suppress the radial growth of phytopathogens viz. Fusarium oxysporum and Alternaria sp. The maximal growth inhibition was observed on the 9th day. The isolate Streptomyces sp. ACT7 showed highest inhibitory activity (11.33±0.47 mm) against Alternaria sp. than against F. oxysporum (10.66±0.94 mm) (fig. 1). Previous studies reported that the fungus showed different responses to chitinase from S. griseus [21]. The present study suggested that the protein composition in the cell walls of different pathogenic fungi might make some fungal cell walls more resistant to chitinolytic degradation. Thus, only the co-culture containing F. oxysporum with Streptomyces sp. ACT7 and Alternaria sp. with Streptomyces sp. ACT7 was selected for SEM analysis. The scanning electron microscopic study showed that there were breakage of the cell walls of F. oxysporum and Alternaria sp. mycelia when acted upon by Streptomyces sp. ACT7 (fig. 2). The previous findings suggested that the extra-cellular secondary metabolites and hydrolytic enzymes, including chitinase play a crucial role in fungal growth inhibition.
Fig. 1: Antifungal activity of actinobacteria ACT7

Fig. 2: Scanning electron microscopic analysis of F. oxysporum co-cultured with Streptomyces sp. ACT7
The antifungal activity of S. hygroscopicus was mainly due to hydrolytic enzymes and secondary thermostable compounds [22]. In addition, there was a report on a positive correlation between chitinolytic and antagonistic activities of Streptomyces against the fungi Collectotrichum sublineolum, Guignardia citricarpa, Rhizoctonia solani and Fusarium oxysporum [23].
CONCLUSION
The present study and the related data revealed that the marine sediments of the ECR of India were the potential source of novel antagonistic actinobacteria they can act as a potential biocontrol agent against phytopathogenic fungi. The growth inhibition of phytopathogenic fungi F. oxysporum and Alternaria sp. by Streptomyces sp. ACT7 was observed and the data proves to be beneficial to treat fungal infections in a systematic manner. However, application of chemical fungicide has many demerits including the development of resistant pathogen and is toxic to soil microbes and animals. Hence, the actiobacteria as biocontrol agents are very good alternative to synthetic fungicides and ecologically friendly approach for the control of phytopathogen.
ACKNOWLEDGEMENT
The authors are thankful to the Management of SRM University, India for providing the necessary facilities and the Tamilnadu State Council for Science and Technology (TNSCAT), Government of Tamilnadu, Chennai for financial assistance.
CONFLICT OF INTERESTS
Declared None
REFERENCES